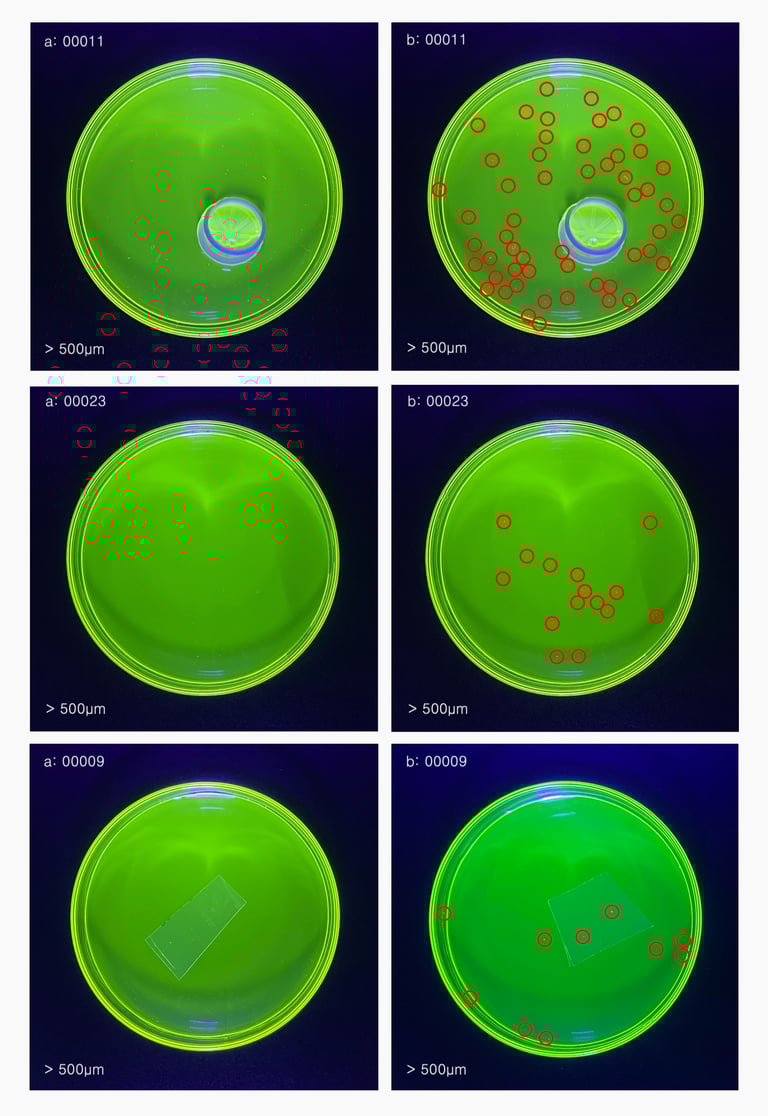
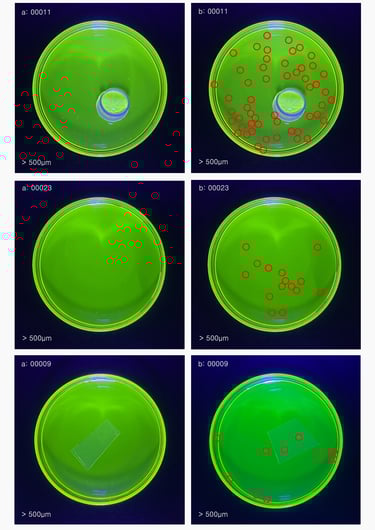

Microplastics generated when opening plastic food packaging
Measuring the impact of Involuntary Plastic Consumption (IPC) on global public health.
Leading the movement to remove microplastics from our food supply.
Peer reviewed evaluations for No-Cut Pack® certification.

Involuntary Plastic Consumption (IPC)
Whereby consumers ingest microplastic transferred into food in the process of cutting or tearing sealed plastic packaging.
The impact on public health is unresolved
Assumptions on the toxicological effects of ingested microplastics are that particles may leach chemicals into the bloodstream.
Insufficient public awareness of MP ingestion
Unregulated product labeling fails to identify food packaging as a mechanism for the uptake of MPs as a transference pathway.
1. Introduction
Microplastics are becoming ubiquitous in our environment. They have been detected everywhere from the air and ocean to fresh water and food. MPs can accumulate in the bodies of the animals and humans that ingest them, and have been linked to serious health consequences, including cancer, birth defects and unwanted immune responses.
Due to its presence in nearly all parts of the biosphere, the potential impact of plastic pollution is not easy to define.
Respiratory and dietary exposure are thought to be the major exposure routes for mammals, with microplastics potentially causing abrasive lesions and inflammatory responses, releasing adsorbed chemicals, or harboring opportunistic pathogens. It has been suggested that only particles < 20 µm may be able to penetrate into the organs.
The results of a research project called Immunoplast [1] found that miniscule pieces of plastic from our environment are absorbed into the human bloodstream. Blood was examined for the presence of five different polymers, the building blocks of plastic.
Dr. Maria Neira, Director of the Department of Public Health, Environment and Social Determinants of Health at WHO.
Polyethylene terephthalate (PET), polyethylene, and polymers of styrene were the most common types of plastic found in the blood samples, followed by poly(methyl methacrylate). Polypropylene was also analysed but the concentrations were too low for an accurate measurement.
The translocation of microplastic particles into tissues has been suggested to occur via the gastrointestinal tract likely by cellular internalization.
Three-quarters of test subjects appeared to have plastics in their blood. The research was the first to prove that plastic particles can end up in the human bloodstream. A quarter of the tested donors had no detectable quantities of plastic particles of any type in their blood.
The overall concentration of plastic particles in the blood of the 22 donors amounted to an average of 1.6 µg/ml, which is comparable to a teaspoon of plastic in 1,000 litres of water (ten large bath tubs).
2. Methods
Our research attempts to answer whether micro- and nanoplastics are created when sealed plastic food packaging is cut open with kitchen shears or a knife.
A low-cost, rapid-screening approach using a green fluorescent dye identifies microplastic fragments as small as 20 micrometers, comparable to the width of a human hair. The dye binds to plastic particles making them easily visible under UV lighting. Fluorescence emission is detected using simple photography. This fluorescence allows us to distinguish microplastic from other natural materials, and quantify their presence. Magnified images allows for particles down to a few micrometers to be detected.
Microplastic Visualization Method
1) Cut open packaging with kitchen shears.
2) Place cut sample in sterile petri dish.
3) Cover with distilled water and green UV reactive dye solution.
4) Agitate sample, then remove.
5) Illuminate with UV blacklight.
Quality Control
Our research into micro- and nanoplastics generated when opening plastic packaging was conducted with minimum sample preparation requirements. To analyze plastics forensically, all laboratory surfaces and equipment were thoroughly cleaned with ethanol. Laboratory trays and petri dishes were new from pre-sealed bags and were carefully checked under a microscope before use for potential contaminants. To remove any contaminants or dust residues all plastic targets were washed with lab detergent, tap water and Milli-Q water in turn and dried at 40 °C before testing. Contaminants were considered negligible and well within the error of the quantification.






3. Discussion
Our work shows that opening plastic packages can generate microplastics, regardless of the opening approach and plastic target, although the opening approach affects the amount of microplastics generated.
Concern exists over whether additives in plastics to which most people are exposed, such as phthalates, bisphenol A or polybrominated diphenyl ethers, may cause harm to human health by altering endocrine function or through other biological mechanisms.
Future studies will elucidate the long term effects of MP uptake on the body, and new insights will be provided into this widespread phenomenon with a particular interest in food safety, security issues, and ultimately human health.
With microplastics generated by ourselves in our daily life as extra sources, we should undertake purchasing responsibility to prevent additional plastic contaminations.
Fluorescence staining provides a fast and easy method to quantify microplastics. Natural organic matter which can be stained by dye and interfere with quantification was eliminated during quality control.
We observed the ubiquity of MPs in a variety of shapes and sizes generated when opening plastic packages.
The amount generated is dependent on conditions such as stiffness, thickness, anisotropy and the density of plastic packaging materials.
While the big microplastics can be identified with the naked eye, smaller ones might be also there.
Of concern is dietary exposure to nano- and microplastic particles at the point of ingestion, and the potential implications for human health.
Our study establishes the transference of microplastics upon cutting which enters the food. If microplastic contaminants carried into the food are then cooked at high temperatures (350-400˚ F), it is yet undetermined what chemicals these plasticized molecules emit and, once consumed, what long-term effects this will have on the body.
In the drive to cut costs manufacturers have moved away from 'peel to open' packaging to vacuum and heat-sealed packs. To access the food, consumers must use a cutting edge. The burden of food safety has been placed on the consumer, albeit unknowingly.
We have termed this effect Involuntary Plastic Consumption (IPC).
4. Results
5. Conclusions
Types of plastic
POLYETHYLENE TEREPHTHALATE
Used for fruit juice containers, soda and water bottles, caps, cooking oil and salad dressing bottles, peanut butter containers.
HIGH-DENSITY POLYETHYLENE
Common type of plastic found in many liquid conatiners like milk jugs.
LOW-DENSITY POLYETHYLENE
Best known for its use in squeezable bottles, bread bags and plastic film food packaging.
POLYPROPYLENE
Commonly used for ketchup bottles, yogurt cups, kitchen containers, straws and medicine bottles.
POLYVINYL CHLORIDE
Commonly referred to as vinyl or PVC is very versatile and usually found in some food packaging.
STYROFOAM (POLYSTYRENE)
Found in egg cartons, disposable cups and single-use dinnerware.
OTHER
Common products include baby bottles, which often contain BPA and LEXAN, both harmful to human health.
Conflicts of Interest
The Index declares it has no known competing financial interests nor personal relationships that influenced the work reported here.
References
We acknowledge these papers in guiding our research.
Data Availability Statement
All data reported here is available upon request. Any dissemination of these results must indicate that it reflects only the Foundation’s view which is not responsible for any use made of the information it contains.
Funding
The Index's work is 100% self-funded and not financially supported by any third parties.




